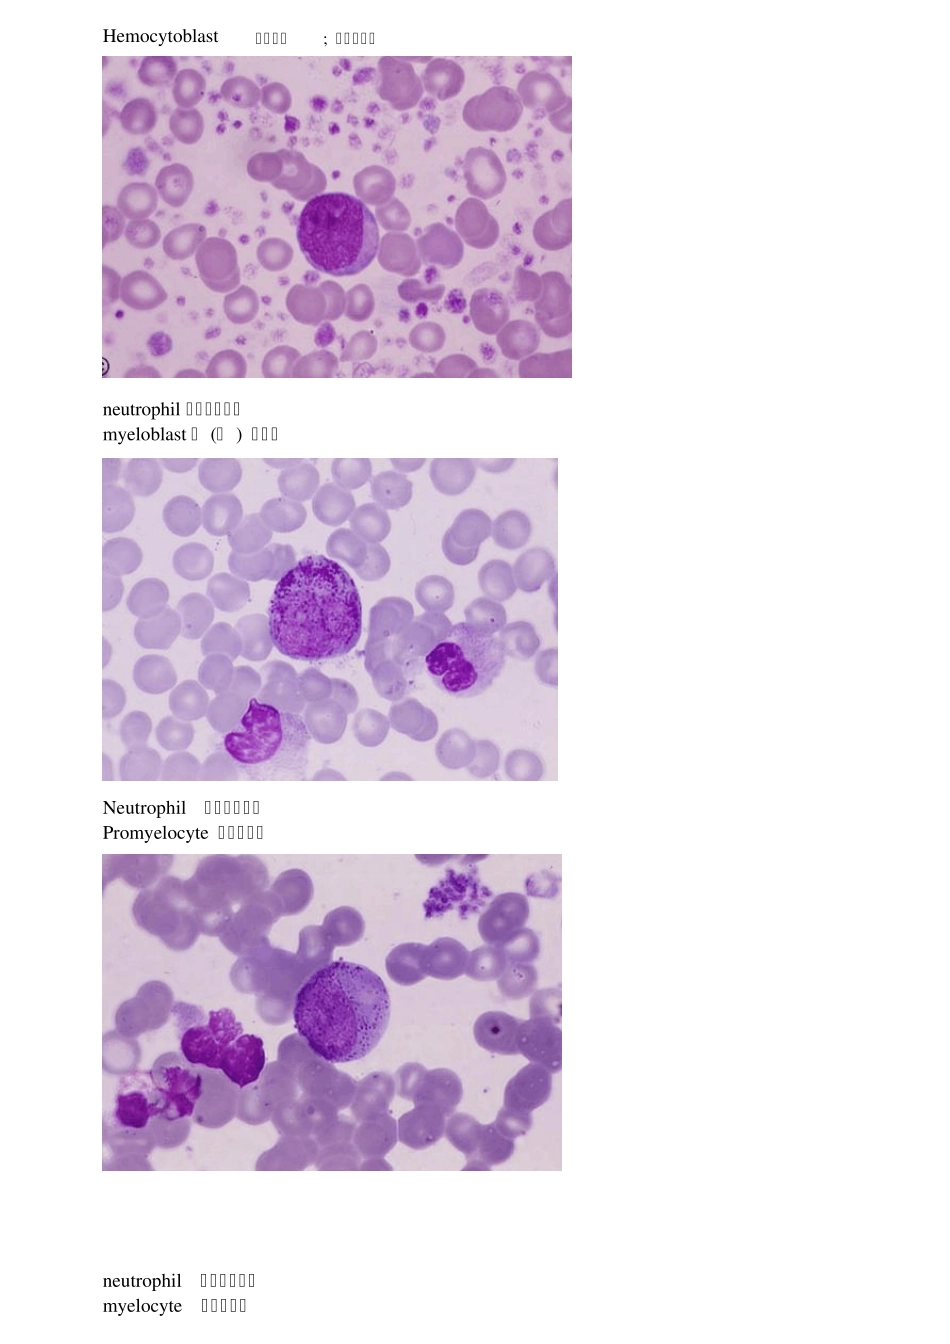
(英文标注)血细胞图谱_第1页

Hemocy toblast 血胚细胞; 原始血细胞 neu trophil 嗜中性粒细胞 my eloblast 原 (始 ) 粒细胞 Neu trophil 嗜中性粒细胞 Promy elocy te 早幼粒细胞 neu trophil 嗜中性粒细胞 my elocy te 中幼粒细胞 Neu trophil ]嗜中性粒细胞 my elocy te 中幼粒细胞 neu trophil ]嗜中性粒细胞 metamy elocy te 晚幼粒细胞 NEUTROPHIL SEGMENTED中性粒细胞 NEUTROPHIL SEGMENTED 中性分叶细胞 NEUTROPHIL MYELOCYTE METAMYELOCYTE BAND SEGMENTED EOSINOPHIL PROMYELOCYTE EOSINOPHIL MYELOCYTE EOSINOPHIL METAMYELOCYTE EOSINOPHIL BAND EOSINOPHIL SEGMENTED EOSINOPHIL SEGMENTED NEUTROPHIL EOSINOPHIL SEGMENTED NEUTROPHIL EOSINOPHIL SEGMENTED BASOPHIL MYELOCYTE BASOPHIL SEGMENTED LYMPHOBLAST PROLYMPHOCYTE LYMPHOCYTE MONOBLAST PROMONOCYTE MONOCYTE MEGAKARIOBLAST PROMEGAKARIOCYTE MEGAKARIOCYTE MEGAKARIOCYTE MEGAKARIOCYTE PLATELETS PLASMOBLAST PROPLASMOCYTE PLASMOCYTE PRO-ERYTHROBLAST PRO-ERYTHROBLAST PRO-ERYTHROBLAST